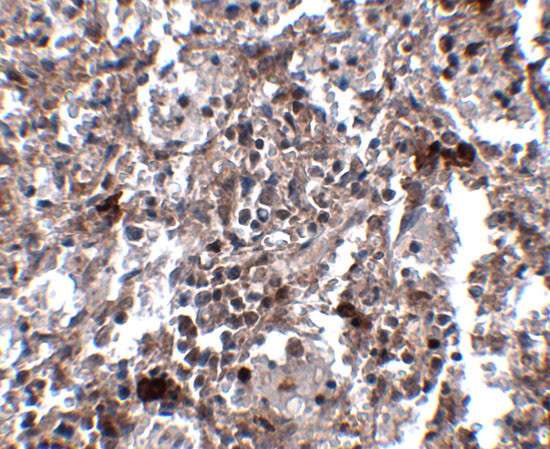
KCTD15 Antibody in Immunohistochemistry (IHC)

Search
Invitrogen
KCTD15 Polyclonal Antibody
{{$productOrderCtrl.translations['antibody.pdp.commerceCard.promotion.promotions']}}
{{$productOrderCtrl.translations['antibody.pdp.commerceCard.promotion.viewpromo']}}
{{$productOrderCtrl.translations['antibody.pdp.commerceCard.promotion.promocode']}}: {{promo.promoCode}} {{promo.promoTitle}} {{promo.promoDescription}}. {{$productOrderCtrl.translations['antibody.pdp.commerceCard.promotion.learnmore']}}



Please note: We are reviewing Western blot images included in the antibody testing data in our catalog, including those provided by third parties. Unless expressly labeled or annotated as “raw-unedited”, Western blot images included in the antibody testing data in our catalog may have been edited, optimized or otherwise adjusted for presentation.
产品信息
PA5-20702
种属反应
宿主/亚型
分类
类型
抗原
偶联物
形式
浓度
规格
纯化类型
保存液
内含物
保存条件
运输条件
RRID
产品详细信息
A suggested positive control is Hela cell lysate.
PA5-20702 can be used with blocking peptide PEP-0817.
靶标信息
Childhood and adult obesity in the United States and to a lesser extent the rest of the world has increased dramatically over the past decade. Both environmental and genetic factors are involved in the onset and progression of weight gain. Recently, the potassium channel KCTD15 was identified as a genetic loci associated with higher than normal body mass index (BMI) in humans along with genes such as GNPDA2, MTCH2, FTO, and TMEM18. Further studies on single nucleotide polymorphisms (SNPs) in non-diabetic and diabetic patients showed that FTO was most strongly associated with obesity while MTCH2 and GNPDA2 were still significantly associated with higher than normal BMI levels. At least two isoforms of KCTD15 are known to exist.
仅用于科研。不用于诊断过程。未经明确授权不得转售。
篇参考文献 (0)
生物信息学
蛋白别名: BTB/POZ domain-containing protein KCTD15; potassium channel tetramerisation domain containing 15; Potassium channel tetramerization domain-containing protein 15
基因别名: BC031749; Kctd15
UniProt ID: (Mouse) Q8K0E1
Entrez Gene ID: (Mouse) 233107, (Rat) 499129